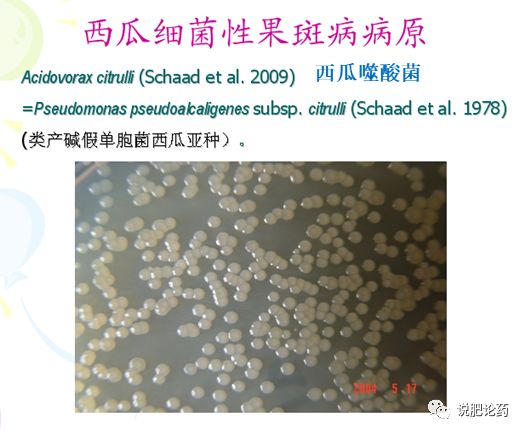
西瓜细菌性果腐病,西瓜细菌性果斑病特效药

在炎炎夏日,吃上一口新鲜的西瓜,可真是再解暑不过了,“清敌炎威退,凉生酒量宽”说的正是西瓜的清爽可人。吃西瓜不仅仅是为了满足自己的口腹之欲,更是对人体有着很大的益处。首先西瓜当中含有大量水分,可以补充我们体内的水分损失,另外,它含有充足的糖分,可以补充体力,供能,而且它含有丰富的维生素、矿物质等对人体有益的营养物质。
但西瓜的生产可不是那么一帆风顺的事情,有很多困扰瓜农的难题!目前我国的西瓜主产区均有一种极具*伤杀**力的病害,老百姓俗称“阴皮病”、“尿炕病”、“果腐病”,每年都会因该病害的防控不利,导致大幅度减产甚至是绝产的事件!——这就是西瓜细菌性果斑病!
病害发生与为害
该病害是发生在西瓜等葫芦科作物上的一种严重的世界性检疫病害,可导致西瓜育苗失败、制种田和商品西瓜田减产,严重的甚至绝产。

西瓜果实上的果斑病症状

在西瓜主产区上述图片这种情况每年都有大量发生,还没熟好的西瓜就被扔出田外,这就是西瓜细菌性果斑病对西瓜生产的巨大威胁!病害一旦发生,很难控制,经常带来巨大的经济损失!
瓜农无辜!瓜农无奈!
说无辜,是因为该病害是种传细菌病害,是我国的检疫性病害,种子检疫是控制该病害远距离传播最有效的手段,只要种子不带菌,细菌性果斑病就不会发生!
说无奈,是因为农民不知道病害是种子带菌引起,也不知道如何处理种子能够控制病害发生,一旦发生,防控难度非常大!
病害分布
该病害于1964年首先发现于美国佛罗里达州的西瓜上。1984-1985年美国西瓜种业公司损失惨重。1989年,此病在美国的商品瓜生产田发生越来越重,扩展至美国的9个州,病害开始大量流行,使西瓜年产量损失达50-90%。到1995年,此病害已蔓延至美国的15个州,有的瓜区由于该病的大发生使80%的瓜不能上市销售。
我国在 20 世纪90 年代首次报道该病害,随后在*疆新**、海南、内蒙古、北京、山东、吉林、辽宁、安徽、福建等地发生并呈上升趋势,造成大田西瓜和甜瓜减产甚至绝收,给我国西瓜生产带来巨大损失。
病原菌与病害循环
该病害为种传细菌病害,病原菌为西瓜噬酸菌。种子表面带菌占98%,种子内部带菌占2%。雨水、风、昆虫和农事操作传播。

西瓜果斑病在苗期即可显示明显病状,并随着农事操作,尤其是浇水进行苗床传播。

苗期出现这种症状的,经检测,均为细菌性果斑病,一定要及时拔除(这是病害苗床传播的根源!!!)并对健康植株进行喷药保护,做到无病苗移栽,减少后期发病。
带菌种子形成的病苗多数是子叶先发病,逐渐传播到真叶上,病斑可沿叶脉扩展,造成叶片上的症状,湿度大时流出白色菌脓,湿度低时病斑干枯,上有薄纸状菌膜。叶片上的菌落到幼果上就侵染果实(开花到花后20天左右),当菌量低时,并不表现症状,病菌也只是附生在植株或果实上,当湿度足够引起病菌大量繁殖时,该病害开始显现症状,并迅速传播蔓延,一旦上果,无法挽救!病瓜率等于损失率!

因此有效做好病害的预防,在西瓜生产中至关重要!因该病害是由种子带菌引起,尤其在前茬作物为玉米等非葫芦科作物时,不存在土壤带菌传播,病害发生中种子带菌是最主要的发病因素。做好种子处理及苗期病害管理,就可大大减轻病害的危害。
防治方法
中国农业科学院植物保护研究所研制了一种专利种子处理剂“杀菌剂1号”,经试验证明对该病害的预防具有非常好的效果,种子处理方法如下:
首先将杀菌剂1号稀释200倍,浸泡西瓜种子1小时,然后用清水冲洗4-5次,每次用水量约为药剂用量的10倍为好,每次用水浸泡时间为10分钟左右。或流水冲洗30分钟,冲洗过程中不断搅拌种子。清洗好的种子可以催芽播种。苗期要管理好以防止种子内部带菌引起发病传播。三倍体西瓜慎重使用。田间防治可用抗生素和铜制剂。
种子处理是最经济最有效的病害防治措施,此药剂防治果斑病亩成本12-15元。防治效果好,病株率减少90%以上。
使用杀菌剂1号处理西瓜种子不仅能够有效防治细菌性果斑病,同时可以减少农药的使用,降低农药残留,保护我们赖以生存的环境(种子处理不出现病株而减少田间用药),对西瓜种植者而言,也是一种福音,希望该项技术能给瓜农带来更多的经济收益,促进西瓜产业可持续发展!
作者:中国农业科学院植物保护研究所赵廷昌、吉林农业大学白庆荣
原创内容,转载请注明出处!
